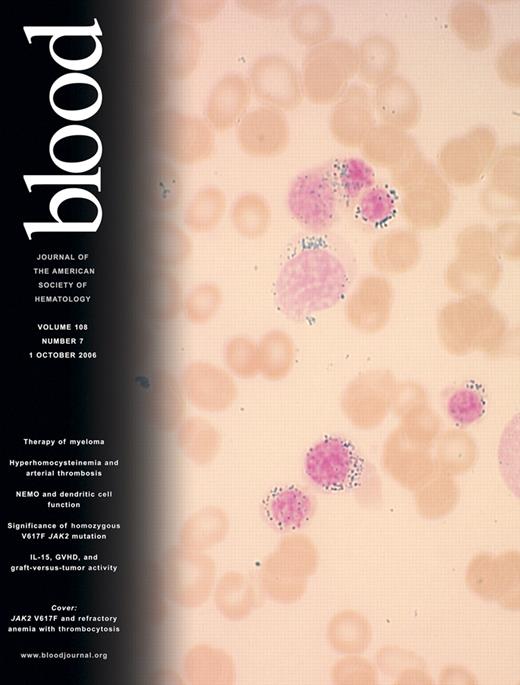

Comment on Nie et al, page 2428
Control of tumor growth by new strategies remains a vital research goal. Nie and associates convincingly demonstrate that expression of mitochondrial ferritin leads to mitochondrial iron sequestration, which inhibits tumor growth in vivo. This work illustrates the potential importance of the mitochondrion in controlling iron metabolism and confirms that iron deprivation is an effective method to prevent cancer growth.
In recent times, the field of iron metabolism has undergone radical changes with the discovery of a range of new proteins that play important roles in the use of this critical nutrient. One of the more intriguing of these molecules is mitochondrial ferritin (MtFt).1 As its name suggests, this protein is found in the mitochondrion and is closely related to the well-known iron storage molecule cytosolic ferritin. The role of MtFt remains unclear, although it appears to sequester iron in diseases such as sideroblastic anemia.2
In this issue of Blood, Nie and colleagues make the intriguing observation that overexpression of MtFt leads to marked mitochondrial iron uptake, which remarkably can be visualized by electron microscopy. Moreover, this enhanced mitochondrial iron sequestration capacity leads to inhibition of tumor growth. These observations are important for 2 reasons. First, they demonstrate that mitochondrial iron metabolism is highly significant and intimately associated with whole-cell iron trafficking. Second, the apparent deprivation of cytosolic iron resulting from high MtFt expression leads to inhibition of tumor growth.
With regard to the unexpected ability of MtFt to alter whole-cell iron metabolism, this finding elucidates a signaling pathway that was previously unknown. Overexpression of MtFt results in cytosolic iron deficiency, as demonstrated by increased RNA-binding activity of the iron regulatory proteins, which leads to increased transferrin receptor 1 and decreased cytosolic ferritin expression. At the same time, there is reduced expression of the mitochondrial protein frataxin. The decrease in frataxin is intriguing, as this protein is down-regulated in the severe neuro/cardiodegenerative disease Friedreich ataxia.3 Decreased frataxin is associated with increased mitochondrial iron accumulation, although its precise role in iron trafficking remains unclear.3 The fact that frataxin expression is altered upon mitochondrial iron uptake and storage adds further weight to the hypothesis that frataxin is integrally involved in iron metabolism.3 At present, it remains unclear how the increase in MtFt signals the marked changes in cellular iron metabolism observed, nor is it known how the iron effectively bypasses the cytosol to result in specific trafficking to the mitochondrion. These questions await further investigation. However, the surprises derived from modulating MtFt suggest our understanding of cellular iron metabolism remains far from complete.
While such a powerful mode of controlling iron metabolism would be tempting to manipulate, the hyperexpression of MtFt cannot be readily achieved in patients to inhibit tumor growth. Recent studies exploring iron deprivation using chelators as a therapeutic strategy against cancer have shown it can be highly effective in vitro and in vivo.4,5 It can be speculated that iron deprivation of the cytosol mediated by overexpression of MtFt prevents tumor growth by inhibiting iron-dependent enzymes such as the rate-limiting step of DNA synthesis, ribonucleotide reductase.5 Moreover, iron depletion leads to increased transcriptional activity of the hypoxia-inducible factor that results in the increased expression of the proapoptotic molecule BNip1 and the metastasis suppressor Nmyc-downstream-regulated gene-1.4,5 Hence, the report by Nie and colleagues confirms that cellular “iron mining” may be a useful strategy to inhibit tumor growth. ▪